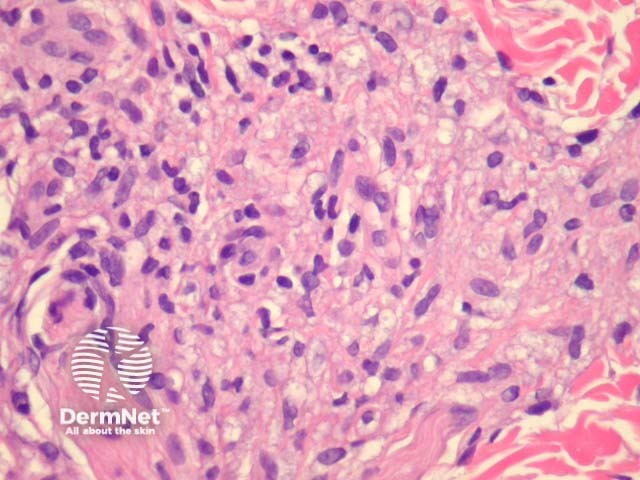
Figure 2

Main menu
Common skin conditions
NEWS
Join DermNet PRO
Read more
Quick links
Infections Diagnosis and testing
Author: Assoc Prof Patrick Emanuel, Dermatopathologist, Auckland, New Zealand, 2013.
Introduction Histology Special studies Differential diagnoses
Leprosy is a chronic bacterial infection caused by Mycobacterium leprae, an obligate intracellular, gram-positive organism. The main clinical types correlate with a specific histopathologic pattern.
Lepromatous leprosy – Underneath a normal epidermis and grenz zone, there are sheets or clusters of macrophages (figure 1). The macrophages have an abundant pink to pale cytoplasm which corresponds to numerous intracellular (parasitized) organisms (figure 2). The associated infiltrate is usually sparse and mainly lymphocytic. In older lesions, the macrophages may have a bubbly cytoplasm (figure 2). As opposed to tuberculoid leprosy, there are not well-formed granulomas or infiltration of nerves.
Tuberculoid leprosy – There is a tuberculoid or sarcoidal granulomatous reaction throughout the dermis consisting of some Langhans giant cells, macrophages in tight clusters, and few accompanying lymphocytes (figure 3). The infiltrate may extensively infiltrate peripheral nerves (figure 4, arrow), vessels, the overlying epidermis and arrectores pilorum.
Indeterminate leprosy – The infiltrate is heavily lymphocytic with smaller numbers of epithelioid histiocytes in clusters. The infiltrate often involves peripheral nerves. Organisms are usually very difficult to find.
Erythema nodosum leprosum – Shows a dense infiltrate which extends into the subcutis, particularly around vasculature. In addition to epithelioid histiocytes with a large pink-bubbly cytoplasm seen in other clinical types, there is a polymorphous population of acute and chronic inflammatory cells.

Figure 1
Figure 2

Figure 3

Figure 4
The leprosy organisms may be demonstrated with a modified Ziehl-Neelsen stain (Wade-Fite). Lesions of lepromatous leprosy will show numerous organisms which are easy to identify. Cases of tuberculoid, indeterminate and erythema nodosum leprosum may prove difficult as the organisms may be scarce. Polymerase chain reaction (PCR) studies may prove useful in confirming the diagnosis of leprosy.
Granulomatous disorders – Tuberculoid leprosy may resemble sarcoidosis or other granulomatous disorders. Special studies and clinical correlation can help in difficult cases.
Histiocytic reactions – The foamy histiocytes, which are laden with organisms in lepromatous leprosy, may mimic histiocytic reactions seen with deposition of aluminium chloride (a common antiperspirant and haemostatic agent) or orthopaedic hardware.
Tuberculosis and other mycobacterial infections – Other mycobacterial infections often cause tissue necrosis and are associated with suppuration. M. avium complex may closely mimic lepromatous leprosy. Special studies may help in the differential.
Lymphoma – T-cell lymphomas may be neurotropic and associated with sparse histiocytes, producing a pattern similar to indeterminate leprosy. Special studies to reveal a T-cell clone and/or isolate the organisms are sometimes needed.